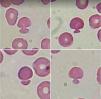

Red cells with cytoplasmic projections, resembling pincer-like cells, also known as mushroom- shaped red blood cells, as Figures 1 and 2, are usually associated with erythrocyte disorders, such as congenital dyserthropoietic anemias, hereditary spherocytosis associated with Banda-3 protein deficiency, disseminated intravascular coagulation, hemolytic-uremic syndrome, thrombotic thrombocytopenic purpura, kidney disease, microangiopathic hemolytic anemia, erythroleukemia and, more rarely, oxidative drug-induced hemolysis. However, a recent study have demonstrated a relationship between these cells and infection caused by Sars-CoV-2 in a pathophysiologic mechanism that possibly involves the occurrence of oxidative stress, which triggers progressive cascade of inflammation, known as citokines storm, that leads to red blood cell damage.1–3
O fator de impacto mede o número médio de citações recebidas em um ano por trabalhos publicados na revista durante os dois anos anteriores.
© Clarivate Analytics, Journal Citation Reports 2025
O CiteScore mede as citações médias recebidas por documento publicado. Mais informação
Ver maisSJR é uma métrica de prestígio baseada na idéia de que todas as citações não são iguais. SJR utiliza um algoritmo similar ao page rank do Google; é uma medida quantitativa e qualitativa ao impacto de uma publicação.
Ver maisSNIP permite comparar o impacto de revistas de diferentes campos temáticos, corrigindo as diferenças na probabilidade de ser citado que existe entre revistas de distintas matérias.
Ver mais